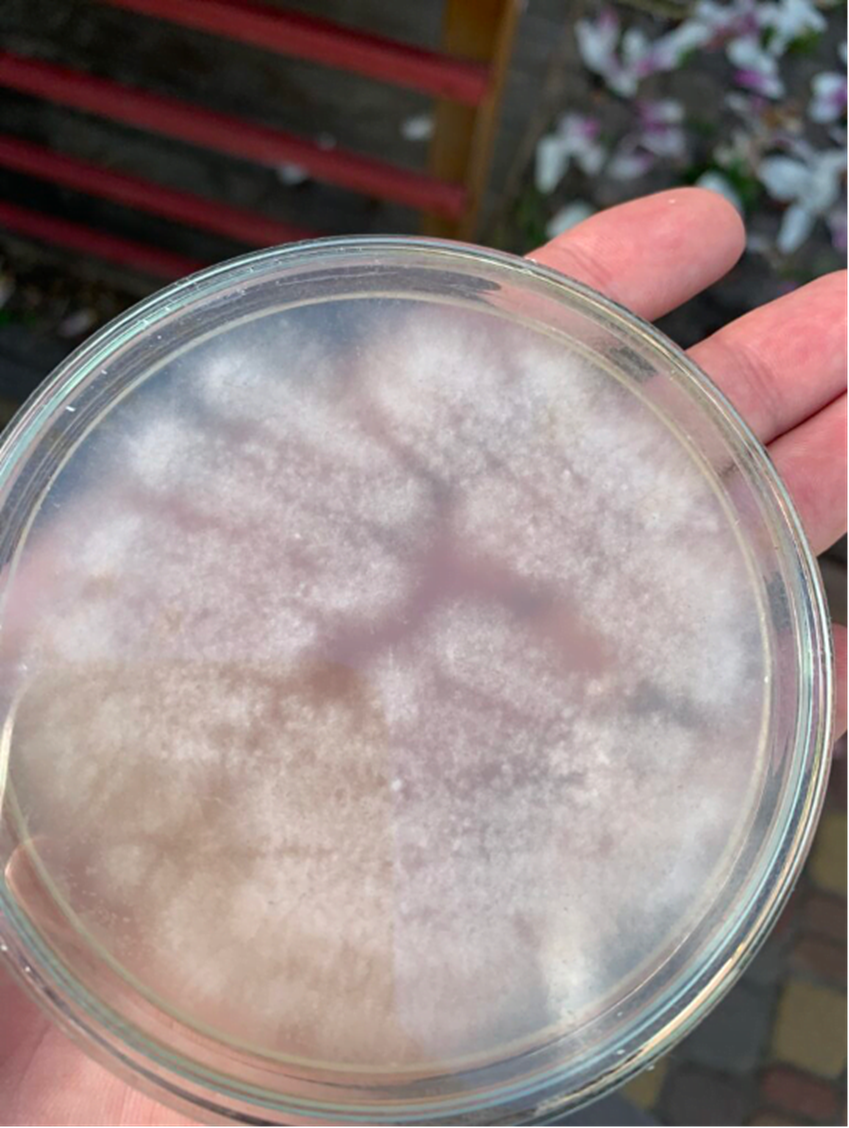
проросшие споры на твердой питательной среде

Твердая питательная среда Light Malt Extract Agar (LMEA) — это простая и популярная питательная среда на агар-агаре. Она используется для выращивания грибов, бактерий и других микроорганизмов. Рецепт очень доступный и включает всего три ингредиента: светлый солодовый экстракт, агар-агар и воду.
Солодовый экстракт содержит витамины, аминокислоты и минералы, которые обеспечивают микроорганизмы всем необходимым. Агар служит основой, превращая раствор в плотную гелеобразную массу. В итоге получается удобная среда, на которой мицелий быстро растёт. Именно поэтому LMEA часто советуют новичкам: приготовить её легко, а результат предсказуемый и стабильный.
Главное условие успеха — аккуратность и стерильность. Все этапы нужно делать по правилам: правильно взвешивать ингредиенты, стерилизовать инструменты и работать в чистых условиях.
Что нужно для работы
Для приготовления твёрдой среды и посева понадобятся:
- вода;
- сухой солодовый экстракт (LME);
- агар-агар;
- чашки Петри;
- марля или бумажный фильтр;
- ёмкость для нагрева и смешивания;
- скороварка или автоклав;
- инкубатор;
- инокуляционная петля или стерильные ватные палочки.
Шаг 1. Приготовление среды
Пропорции ингредиентов:
| Вода | LME | Agar |
| 250 ml | 5 g | 5 g |
| 500 ml | 10 g | 10 g |
| 750 ml | 15 g | 15 g |
| 1000 ml | 20 g | 20 g |
Смешайте компоненты в ёмкости, хорошо размешайте. Нагревайте в микроволновке 5–10 минут, доставая каждые 30–60 секунд и перемешивая. Важно довести раствор до закипания, но не кипятить долго.
После нагрева можно профильтровать смесь через марлю или бумажный фильтр (по желанию). Затем перелейте раствор в банку с крышкой, в которой сделано небольшое отверстие, заклеенное пластырем.
Стерилизовать нужно в скороварке около 40 минут вместе с чашками Петри и инструментами для посева (ватные палочки). После стерилизации дайте остыть и подготовьтесь к разливке.

Шаг 2. Разливка по чашкам Петри
Работать нужно максимально стерильно. Лучше всего использовать бокс для чистых работ. Если бокса нет, можно обработать помещение кварцевой лампой в течение 40–60 минут. Полной стерильности это не даст, но снизит риск заражения.
Остывший агар разливают по чашкам Петри (примерно 15–20 мл на чашку). Температура смеси должна быть около 40 °C: если горячее — появится конденсат, если холоднее — агар быстро застынет.
После разливки закройте крышки и дайте агару полностью застыть. Теперь среда готова к посеву.

Шаг 3. Инокуляция
На агар можно высевать споры или использовать споровую взвесь. Самое важное — стерильность.
- Инструменты. Петлю перед работой прокаливают до красна. Ватные палочки можно использовать одноразовые, предварительно простерилизовав их в скороварке.
- Споры. Их можно нанести штрихами, буквой S или просто посыпать с бумажки. Штриховой метод помогает лучше разделить колонии.
- Споровая взвесь. Достаточно капнуть несколько капель раствора на поверхность.
После посева чашки заклеивают пластырем или омнипором по кругу и ставят в инкубатор при 28–30 °C (зависит от вида гриба). Первые признаки роста мицелия обычно заметны уже через 3–5 дней.


Итог
LMEA — это простой и надёжный способ получить питательную среду для работы с грибами и микроорганизмами. При соблюдении стерильности и правильных пропорций можно добиться хорошего и стабильного роста мицелия даже в домашних условиях. У нас есть также статья про приготовление жидкой питательной среды.